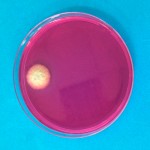
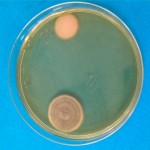
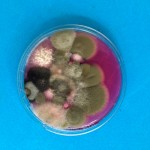
muestra hongos

Higiene ambiental: Que los hongos no destruyan la historia
Hace un tiempo realizamos un trabajo muy interesante en un depósito archivístico sobre la contaminación fúngica en carpetas donde se archivaban documentos históricos (documentos con hasta seis siglos de antigüedad).
En primer lugar, se recopilo una serie de carpetas donde se apreciaban unas manchas peculiares, tras la realización de una observación microscópica de las preparaciones obtenidas de dichas manchas y el estudio de sus estructuras morfológicas pudimos concluir que se trata de contaminación fúngica.
Según los resultados obtenidos, a través de otros procedimientos que incluyeron medios de cultivo e incubación de los hongos en varias fases, pudimos concluir que las manchas encontradas en la carpeta analizada corresponden a hongos filamentosos de los siguientes géneros: Penicillium spp, Aspergillus spp, Cladosporium spp, Rhizopus spp.
Es muy interesante tener en cuenta que el lino era una fibra vegetal muy frecuente para fabricar papel hasta 1850. La escasez que este material empezó a experimentar forzó que se buscaran nuevas formas de producirlo y nuevas materias primas como la pulpa o pasta de celulosa, proveniente de la madera de los árboles. Esta fibra de celulosa unas décadas más tarde necesitaba el ácido sulfúrico o el ácido acético para su tratamiento o los ácidos clorados para el blanqueamiento.
La temperatura, la humedad y la luz son elementos ante los que estos ácidos reaccionan con el amarillamiento de las hojas de papel y otros efectos biológicos como la formación de hongos, bacterias e infestación de insectos.